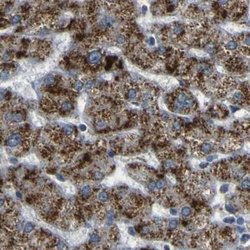
Invitrogen ACBD5 Polyclonal Antibody 100 &mu;L; Unconjugated:Antibodies,

Learn More
Invitrogen™ ACBD5 Polyclonal Antibody


Rabbit Polyclonal Antibody
Brand: Invitrogen™ PA552861
Description
Immunogen sequence: IQVPPGNGNI GNMQVVAVEG KGEVKHGGED GRNNSGAPHR EKRGGETDEF SNVRRGRGHR MQHLSEGTKG RQVGSGGDGE RWGSDRGSRG SLNEQIALVL MRLQEDMQNV LQRLQKLETL TALQAKSSTS TLQTAPQPTS QRPSWWPF Highest antigen sequence identity to the following orthologs: Mouse - 80%, Rat - 81%.
Acyl-CoA binding protein which acts as the peroxisome receptor for pexophagy but is dispensable for aggrephagy and nonselective autophagy. Binds medium- and long-chain acyl-CoA esters.
Specifications
| ACBD5 | |
| Polyclonal | |
| Unconjugated | |
| ACBD5 | |
| 1300014E15Rik; Acbd5; acyl-CoA binding domain containing 5; acyl-CoA-binding domain-containing protein 5; acyl-Coenzyme A binding domain containing 5; endozepine-related protein; KIAA1996; membrane-associated diazepam binding inhibitor | |
| Rabbit | |
| Antigen Affinity Chromatography | |
| RUO | |
| 91452 | |
| Store at 4°C short term. For long term storage, store at -20°C, avoiding freeze/thaw cycles. | |
| Liquid |
| Immunohistochemistry (Paraffin), Western Blot, Immunocytochemistry | |
| 0.1 mg/mL | |
| PBS with 40% glycerol and 0.02% sodium azide; pH 7.2 | |
| Q5T8D3 | |
| ACBD5 | |
| Recombinant protein corresponding to Human ACBD5. Recombinant protein control fragment (Product #RP-90096). | |
| 100 μL | |
| Primary | |
| Human | |
| Antibody | |
| IgG |
Your input is important to us. Please complete this form to provide feedback related to the content on this product.